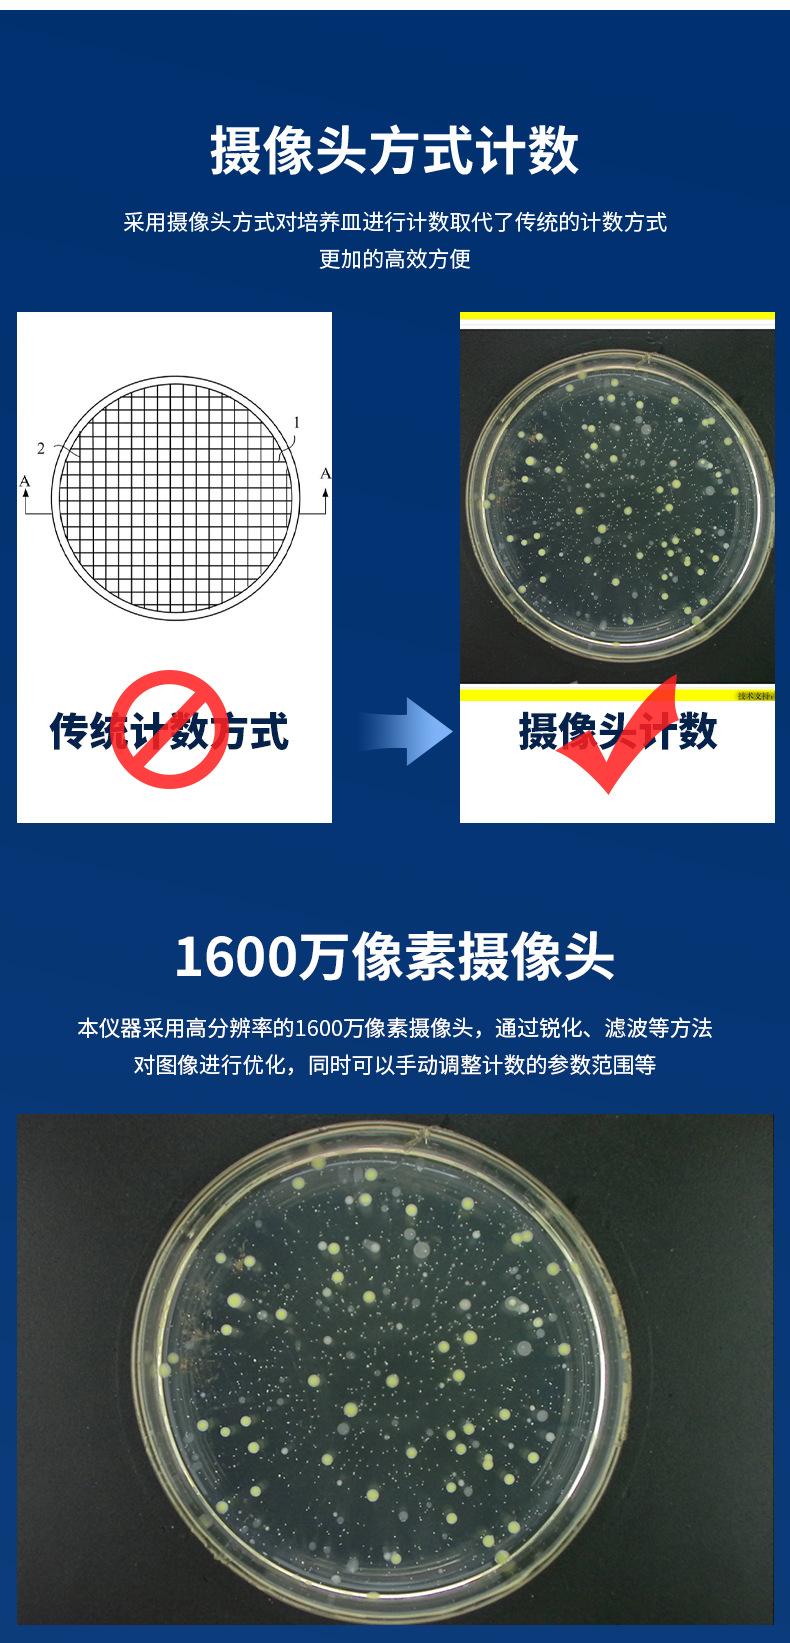

El texto en las imágenes se puede traducir
Contador de colonias automático portátil tipo LB-6300, detector de bacterias para la higiene alimentaria y el monitoreo ambiental.
Precio por pieza incluyendo entrega a México
Cantidad
Producto seleccionado
Especificaciones del producto
Origen
Qingdao
Tamaño
See details
Precisión de detección
0.1
Tipo
LB-6300 Portable Automatic Colony Counter
Marca
Lubo.
Ámbito de aplicación
Laboratory, etc.
Modelo
LB-6300
Peso
10
Origen
Qingdao
Tamaño
See details
Precisión de detección
0.1
Tipo
LB-6300 Portable Automatic Colony Counter
Marca
Lubo.
Ámbito de aplicación
Laboratory, etc.
Modelo
LB-6300
Peso
10
Origen
Qingdao
Tamaño
See details
Precisión de detección
0.1
Tipo
LB-6300 Portable Automatic Colony Counter
Marca
Lubo.
Ámbito de aplicación
Laboratory, etc.
Modelo
LB-6300
Peso
10
Detalles del producto
El texto en las imágenes se puede traducir

Total
Entrega
IVA
Otro